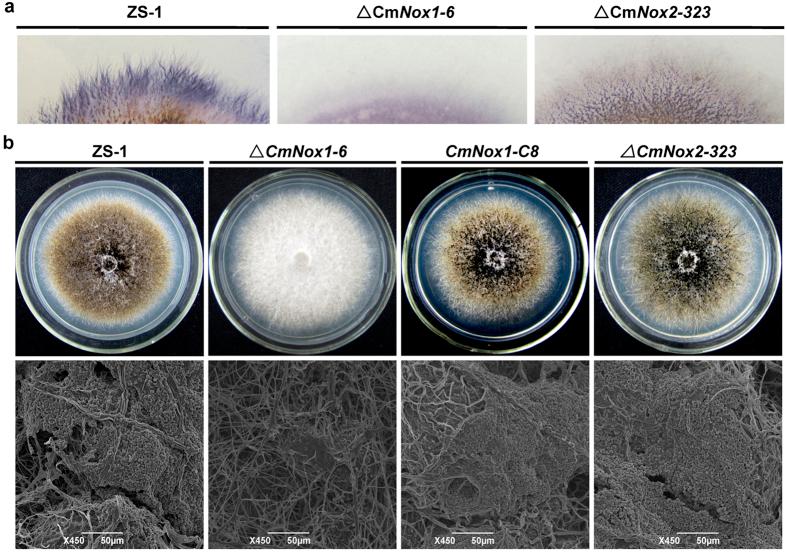
https://cdn.ncbi.nlm.nih.gov/pmc/blobs/bd28/4828707/5a0ae8908c8b/srep24325-f1.jpg
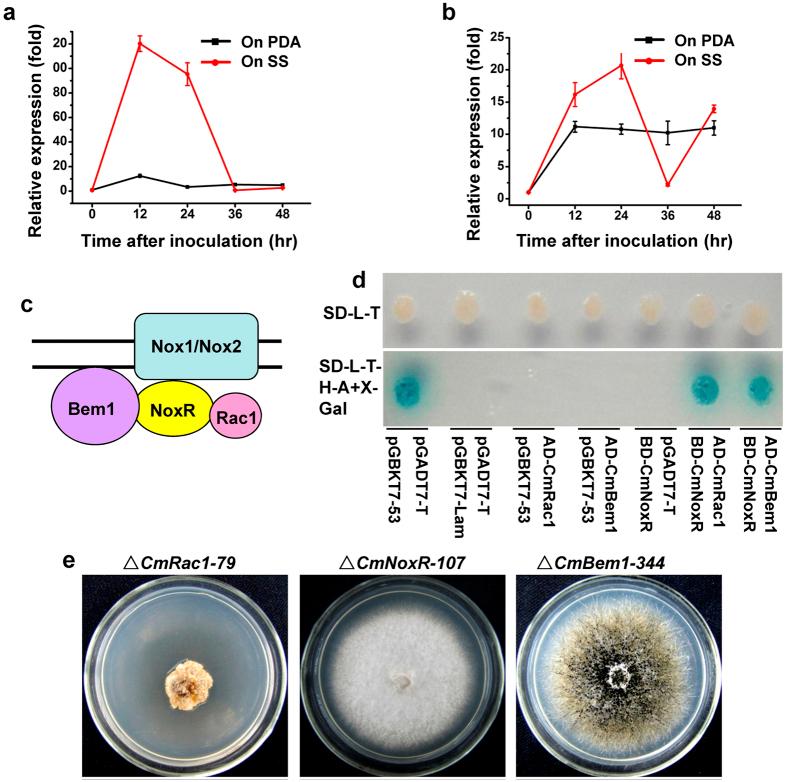
https://cdn.ncbi.nlm.nih.gov/pmc/blobs/bd28/4828707/a0008c890dc9/srep24325-f3.jpg

Nox复合体信号与丝裂原活化蛋白激酶(MAPK)级联途径相互交联,对食真菌性病原菌微小盾壳霉的致病性和分生孢子形成至关重要。
Nox Complex signal and MAPK cascade pathway are cross-linked and essential for pathogenicity and conidiation of mycoparasite Coniothyrium minitans.
作者信息
Wei Wei, Zhu Wenjun, Cheng Jiasen, Xie Jiatao, Jiang Daohong, Li Guoqing, Chen Weidong, Fu Yanping
机构信息
State Key Laboratory of Agricultural Microbiology, Huazhong Agricultural University, Wuhan 430070, Hubei Province, P R China.
The Provincial Key Lab of Plant Pathology of Hubei Province, College of Plant Science and Technology, Huazhong Agricultural University, Wuhan, 430070, Hubei Province, P R China.
出版信息
Sci Rep. 2016 Apr 12;6:24325. doi: 10.1038/srep24325.
The NADPH oxidase complex of a sclerotial mycoparasite Coniothyrium minitans, an important biocontrol agent against crop diseases caused by Sclerotinia sclerotiorum, was identified and its functions involved in conidiation and mycoparasitism were studied. Gene knock-out and complementary experiments indicated that CmNox1, but not CmNox2, is necessary for conidiation and parasitism, and its expression could be significantly induced by its host fungus. CmNox1 is regulated by CmRac1-CmNoxR and interacts with CmSlt2, a homolog of Saccharomyces cerevisiae Slt2 encoding cell wall integrity-related MAP kinase. In ΔCmNox1, CmSlt2-GFP fusion protein lost the ability to localize to the cell nucleus accurately. The defect of conidiation in ΔCmRac1 could be partially restored by over-expressing CmSlt2, indicating that CmSlt2 was a downstream regulatory factor of CmNox1 and was involved in conidiation and parasitism. The expressions of mycoparasitism-related genes CmPks1, Cmg1 and CH1 were suppressed in the knock-out mutants of the genes in CmNox1-CmSlt2 signal pathway when cultivated either on PDA. Therefore, our study infers that CmRac1-CmNoxR regulates CmNox1-CmSlt2 pathway in regulating conidiation and pathogenicity of C. minitans.
盾壳霉是一种重要的防治由核盘菌引起的作物病害的生防菌,其NADPH氧化酶复合体已被鉴定,并对其在产孢和菌寄生过程中的功能进行了研究。基因敲除和互补实验表明,产孢和寄生过程需要CmNox1,而非CmNox2,且其表达可被其寄主真菌显著诱导。CmNox1受CmRac1-CmNoxR调控,并与酿酒酵母Slt2的同源物CmSlt2相互作用,CmSlt2编码与细胞壁完整性相关的丝裂原活化蛋白激酶。在ΔCmNox1中,CmSlt2-GFP融合蛋白失去了准确定位于细胞核的能力。过表达CmSlt2可部分恢复ΔCmRac1中产孢缺陷,表明CmSlt2是CmNox1的下游调控因子,参与产孢和寄生过程。当在PDA上培养时,CmNox1-CmSlt2信号通路中基因的敲除突变体中,菌寄生相关基因CmPks1、Cmg1和CH1的表达受到抑制。因此,我们的研究推断,CmRac1-CmNoxR在调控盾壳霉的产孢和致病性过程中调节CmNox1-CmSlt2通路。